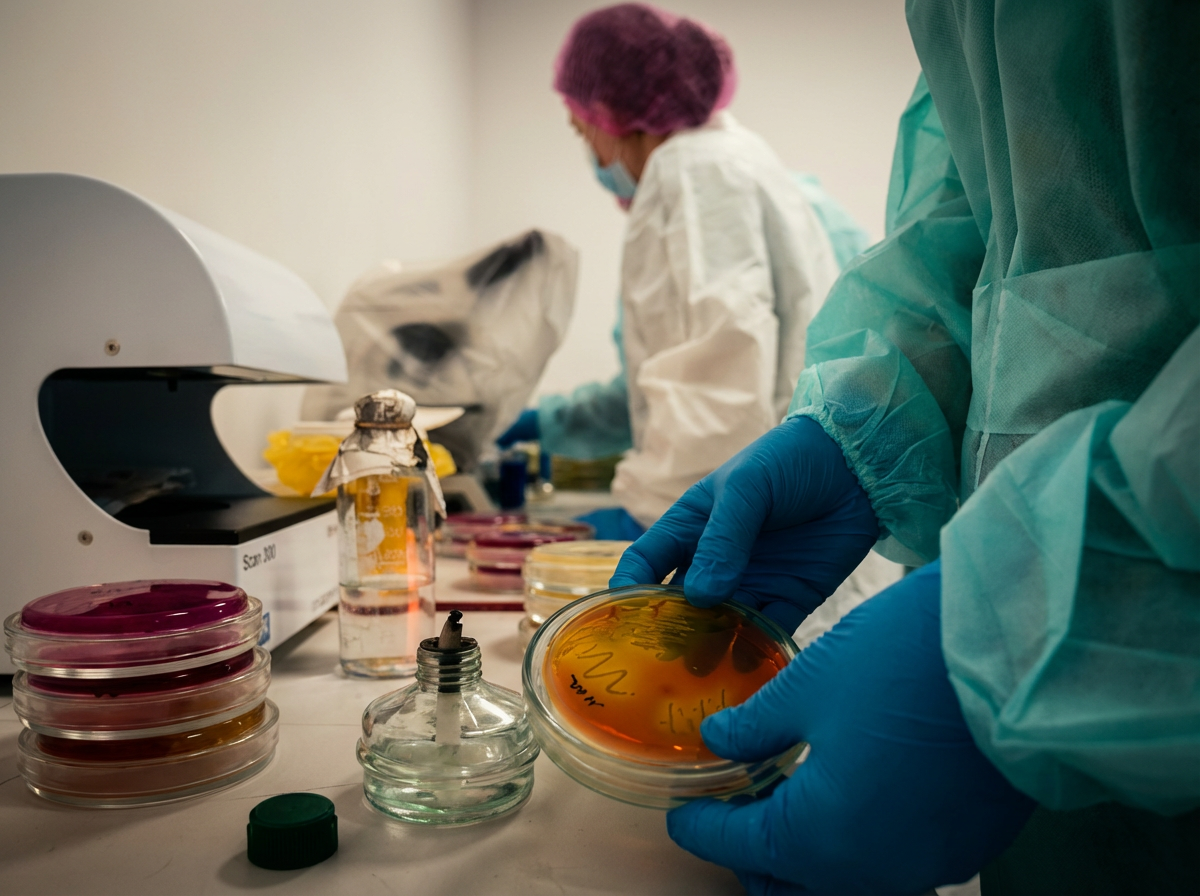

Роль ветеринарной лаборатории в системе национальной безопасности: интервью с генеральным директором
Как поддерживать высокие стандарты работы в сети лабораторий, охватывающей всю страну? В интервью с генеральным директором РГП РВЛ Темирханом Елшибаевым обсуждается практический опыт развития государственного предприятия. Узнайте, как интеграция Clockster позволила наладить прозрачный учет рабочего времени для тысяч специалистов и упростить административные процессы.
Karina Dargulova
8 янв. 2026 г.
Когда речь заходит о ветеринарной службе, большинство людей по-прежнему представляют себе узкую отраслевую функцию, связанную исключительно с сельским хозяйством и животными. На практике же, ветеринарная лабораторная система – это один из ключевых элементов национальной безопасности, напрямую влияющий на здоровье людей, устойчивость продовольственного рынка, а также на экспортно-импортный потенциал страны.
Особо опасные заболевания, эпизоотии, заражённые партии продукции, трансграничные угрозы – всё это не абстрактные риски, а реальные сценарии, с которыми государство сталкивается регулярно. В таких условиях роль лабораторной диагностики становится критической: именно она позволяет выявлять угрозы на ранней стадии – и предотвращать масштабные последствия.

В Казахстане эту функцию выполняет РГП на ПХВ «Республиканская ветеринарная лаборатория» – крупнейшая государственная разветвленная сеть ветеринарных лабораторий, работающие на стыке науки, контроля и практической безопасности. Под руководством генерального директора Елшибаева Темирхана действующая инфраструктура предприятия была системно усилена и объединена за счёт внедрения новых бизнес-процессов и управленческих подходов, что повысило её управляемость и уровень постоянной готовности по всей стране.
Эта статья – не о технологиях. Она – о людях и процессах, которые остаются вне поля зрения, но именно они определяют безопасность пищевой продукции, устойчивость рынка и здоровье общества. Ведь мы есть то, что потребляем – и от качества животноводческой продукции напрямую зависит будущее здорового поколения.
РГП РВЛ: масштаб, который редко виден снаружи
РГП на ПХВ «Республиканская ветеринарная лаборатория» – это не одна лаборатория и не один город. Это разветвлённая система, охватывающая всю страну: центральный аппарат, областные и региональные филиалы, районные подразделения, работающие в постоянном контакте с ветеринарными службами, агропредприятиями и личными подсобными хозяйствами.
Фактически РГП РВЛ – это первичное сито лабораторного контроля, ежегодно пропускающее через себя огромный объем диагностических исследовании на особо опасные заболевания животных, мониторинг безопасности продукцию животного происхождения и контроля рисков, связанных с трансграничным перемещением сырья и товаров.
В системе работают сотни специалистов: это люди, от которых требуется не просто профессиональная подготовка, но и высокая дисциплина, точность и готовность работать в условиях повышенной ответственности. Ошибка в лабораторной диагностике – это не внутренний сбой, а потенциальная угроза для национальной безопасности.
Мы работаем с рисками, которые не допускают отсрочек: либо решения принимаются своевременно и точно, либо последствия носят системный характер,
– отмечает генеральный директор РГП РВЛ Темирхан Елшибаев.

При этом нагрузка на систему постоянно растёт. Увеличивается объём исследований, усложняются методы диагностики, усиливаются требования со стороны международных организаций. РГП РВЛ сегодня – это структура, которая одновременно должна соответствовать научным стандартам, государственным регламентам и реальным условиям рынка.
Именно в таком контексте вопрос управления – людьми, процессами, ресурсами, перестаёт быть вспомогательным. Он становится базовым условием устойчивости всей системы.
Система в цифрах: лабораторная сеть по всей стране.
Чтобы понять реальный масштаб РГП РВЛ, достаточно посмотреть на цифры. Сегодня это одна из самых крупных и территориально распределённых лабораторных систем в сфере ветеринарии страны.
В структуре Республиканской ветеринарной лаборатории работают более 2 500 специалистов разного профиля, которые обеспечивают непрерывную работу лабораторий по всей республике.
Лабораторная сеть охватывает 188 объектов лабораторной деятельности, включая:
– 17 областных и региональных филиалов,
– 149 районных и зональных лабораторий,
– 22 пункта приема проб биологического и патологического материала.
Этот масштаб означает одно: любая ошибка, задержка или сбой в работе отражается не локально, а системно – на уровне регионов, отраслей и внешнеэкономических связей. Поэтому для РГП РВЛ критически важно, чтобы каждый участок цепочки – от районной лаборатории до центрального аппарата, работал синхронно и по единым стандартам.

При наличии сотен лабораторий и тысяч сотрудников, управление не может опираться на интуицию – требуется системно выстроенная модель, охватывающая методики, процессы и кадровую работу,
– отмечает Темирхан Елшибаев.
Именно эта масштабность превращает РГП РВЛ из обычного государственного предприятия в инфраструктурный элемент, без которого невозможно говорить о стабильной ветеринарной и продовольственной безопасности страны.
Что стоит за работой РГП РВЛ: ежедневная ответственность, а не формальные проверки
Работа Республиканской ветеринарной лаборатории редко бывает на виду, но именно она формирует базу для решений в сельском хозяйстве, пищевой промышленности и экспортно-импортных операциях. Это не про разовые проверки – это про постоянный контроль рисков.

РГП РВЛ ежедневно проводит лабораторные исследования по ключевым направлениям ветеринарной безопасности: диагностика инфекционных и особо опасных заболеваний животных, контроль безопасности продукции животного происхождения, мониторинг эпизоотической ситуации, а также сопровождение внешнеторговых поставок.
Через лаборатории проходят образцы мяса, молока, кормов, биоматериала, продукции для экспорта и импорта. От корректности результатов зависит не только судьба конкретной партии, но и репутация страны на международных рынках.
Наша сфера не допускает работы с предположениями – точность данных напрямую определяет уровень отраслевых рисков,
– подчёркивает Темирхан Елшибаев.
При этом лаборатории функционируют в разных условиях – от крупных областных филиалов до районных филиалов. Уровень нагрузки, количество исследований, состав сотрудников могут отличаться, но требования к качеству и срокам остаются стандартизировано одинаковыми для всех. Именно поэтому для РГП РВЛ важно не просто наличие специалистов и оборудования, а единая управляемая система, где каждый сотрудник понимает свою роль, график, зону ответственности и работает в рамках четких стандартов.
Управление людьми в масштабах страны: где заканчивается ручной контроль
Когда в системе работают тысячи сотрудников и почти двести подразделений, классические управленческие подходы перестают работать. Невозможно держать всё в голове, опираться на устные договорённости или ручные отчёты – слишком высокая цена ошибки.
Для РГП РВЛ ключевой вызов всегда был не в отсутствии регламентов, а в обеспечении их исполнения на всей территории страны. Сотрудники работают в разных регионах, в разном темпе, с разной нагрузкой, но требования к дисциплине, присутствию и соблюдению графиков – единые для всех.
Когда система растянута на всю страну, управлять “на глаз” уже невозможно – нужны единые и прозрачные правила для всех,
– говорит Темирхан Елшибаев.

Особую сложность создаёт специфика работы лабораторий. Здесь важно не просто выйти на работу, а быть на месте строго в определённое время, чтобы обеспечить непрерывность исследований, приём образцов и соблюдение сроков. Любое опоздание или отсутствие одного специалиста может повлиять на работу всей цепочки.
При этом ручной контроль – через звонки, переписки и отчёты, создаёт дополнительную нагрузку на руководителей и административный персонал. Вместо управления процессами они вынуждены заниматься постоянной проверкой факта присутствия. Именно на этом этапе в РГП РВЛ стало очевидно: для устойчивой работы такой структуры необходимы цифровые инструменты, которые позволяют перейти от контроля «вручную» к управлению на основе объективных данных.
Цифровая опора: автоматизация как часть зрелого управления
Переход к цифровым инструментам в РГП РВЛ не был резким или вынужденным. Это был логичный шаг в развитии уже выстроенной системы, где регламенты и требования существовали давно, но их исполнение на масштабе страны требовало более точных и единых механизмов.
Автоматизация здесь рассматривалась не как способ усилить контроль, а как инструмент, который позволяет снять нагрузку с управленческой вертикали и перейти к работе с фактами, а не предположениями. Фиксация присутствия, соблюдение графиков, прозрачность рабочего времени – всё это стало частью единого цифрового контура.
Сегодня в РГП РВЛ используются современные инструменты автоматизации, в том числе clockster – как решение для учёта посещаемости и базовой дисциплины персонала. Система органично встроилась в повседневную работу лабораторий и административных подразделений, не меняя саму суть процессов, но делая их более предсказуемыми.
Ключевая задача заключалась в том, чтобы внедряемый инструмент не дестабилизировал действующую систему, а усиливал её за счёт прозрачных и единых правил работы,
– отмечает Темирхан Елшибаев.

Цифровая фиксация присутствия позволила руководству видеть общую картину по подразделениям, а линейным руководителям – быстрее реагировать на отклонения, не тратя время на уточнения и ручные проверки. При этом для сотрудников правила стали более понятными и одинаковыми для всех – независимо от региона или уровня подразделения.
При наличии десятков лабораторий и сотен сотрудников эффективное управление возможно только на основе системных процессов, а не ручного контроля,
– подчёркивает генеральный директор РГП РВЛ.
Важно отметить, что в РГП РВЛ, опираясь на собственный потенциал, расширило функциональные возможности действующей системы, интегрировав между собой два независимых решения – Clockster и 1С. Это позволило автоматизировать передачу данных о посещаемости и рабочем времени в бухгалтерские и кадровые контуры. Помимо этого, создали дополнительные инструменты для работающих по договору ГПХ – теперь из clockster в 1С выгружаются данные по отработанным дням и суммам за месяц для автоматической генерации Актов выполненных работ (АВР). Это упростило расчёт заработной платы и снизило нагрузку на административные подразделения – данные синхронизируются без ручных выгрузок и дублирования.
Автоматизация в данном случае стала не самоцелью, а инфраструктурным элементом, который поддерживает устойчивость всей системы и снижает зависимость от человеческого фактора.
Заключение: когда масштаб требует системности
РГП на ПХВ «Республиканская ветеринарная лаборатория» – это не просто государственное предприятие и не набор лабораторий по регионам. Это одна из ключевых инфраструктур страны, от работы которой напрямую зависят ветеринарная и продовольственная безопасность, устойчивость аграрного сектора и доверие к казахстанской продукции под брэндом «Made in KZ» на международных рынках.
Сегодня в системе РГП РВЛ работают более 2 500 сотрудников по всей стране – специалисты, которые ежедневно выполняют критически важную работу в условиях высокой ответственности и строгих регламентов. Управление таким масштабом невозможно без чётких процессов, единых правил и прозрачных механизмов, которые позволяют системе работать стабильно – независимо от региона, нагрузки и внешних факторов.
Именно поэтому, автоматизация в подобных организациях перестаёт быть вопросом удобства и становится необходимостью. Она не заменяет управленческие решения и не подменяет профессионализм людей, но создаёт ту самую опору, без которой невозможно обеспечить порядок, дисциплину и предсказуемость на уровне всей страны. В РГП РВЛ цифровые инструменты органично встроены в существующую управленческую логику и помогают поддерживать устойчивость системы в ежедневной работе.
Для команды clockster сотрудничество с РГП РВЛ – это большая ответственность и честь. Мы благодарны за доверие и возможность быть частью инфраструктуры, которая играет столь важную роль для государства и общества. Именно такие проекты наглядно показывают, что системное управление и современные инструменты – это не про технологии ради технологий, а про устойчивость, безопасность и долгосрочное развитие.

